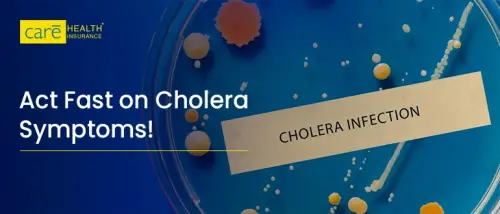
Act Fast! Decode Cholera Symptoms Before It’s Too Late Act Fast! Decode Cholera Symptoms Before It’s Too Late

Subscribe to get weekly insights
Always stay up to date with our newest articles sent direct to your inbox
Nidhi comes with versatility in writing about education, health, motivation, and many more industries. Her 6+ years of experience make her competent at educating readers about insurance, and covering their health and travel insurance related queries.
From the core, she lives a spiritual life, spreading peace all around. Moreover, apart from writing web and print content, writing poems recreates her creativity and passion for writing.

Ever noticed how, on some days, your mind feels clear and calm, while on others you feel tense or low?...

You’ve probably noticed gluten-free diets all over social media, often promoted as a lifestyle choice, sometimes as a wellness hack....

Fast food binges, late-night Netflix, and energy drinks as a quick fix to make it through long nights- sound familiar?...

There’s a secret ingredient that keeps your skin radiant, your mood lifted, and your thyroid in balance, yet it’s silently...

From the desi tawa to the trending table, green capsicum has seen it all. Once diced and dismissed in home-cooked...
In today’s fast-paced life, we often brush off dehydration, fatigue or stomach issues as part of the grind. Isn’t it?...

For centuries, European grandmothers have relied on elderberries, also known as “Sambucus”, which derives its name from the Greek word...

Instant Cover Plus is Here with No-Wait PED Coverage! Care Health Insurance is launching a new add-on benefit, Instant Cover...

“Have you ever checked your medical bill and wondered why certain charges are labelled as “copay” while others show up...

When it comes to a crunchy, nutritious addition to your diet, celery is a true powerhouse. The benefits of celery...

Understanding insurance terms can be confusing, especially when it comes to Policy Year, Policy Tenure, and Policy Lifetime in Insurance....

Every year on October 31, the world celebrates World Cities Day, an initiative by the United Nations that highlights the...
Page 1 of 11
Loading...